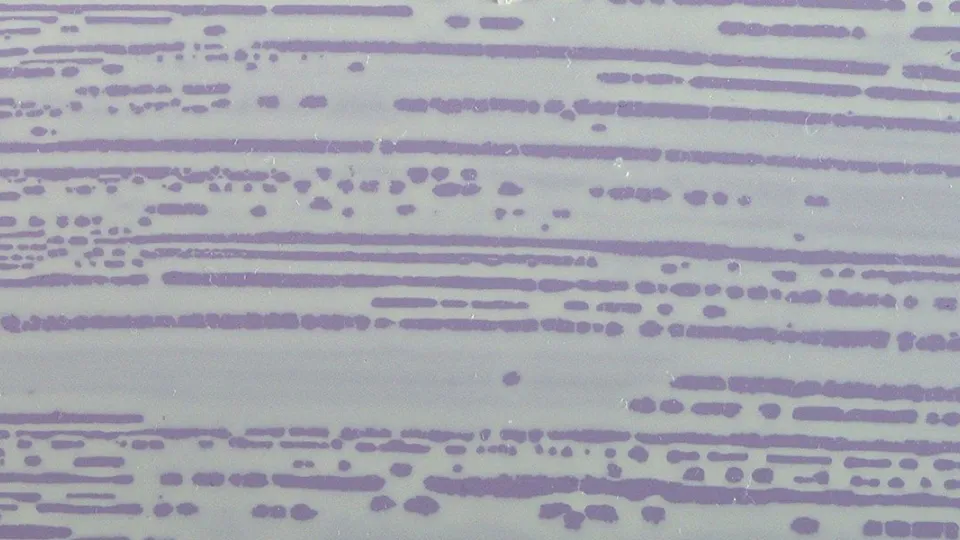
Maali ei tartu

Yleisimmät haasteet maalauksessa
Näillä ohjeilla voit ehkäistä, tunnistaa ja korjata maalipinnoilla yleisimmin ilmeneviä virheitä.
Jokainen sivu sisältää kuvan ja selostuksen ongelmasta, luettelon sen mahdollisista syistä sekä ratkaisuehdotuksen.
Jos et tiedä, mistä ongelmasta on kyse, ota yhteys Maalilinjaan puhelimitse tai sähköpostilla. Parhaiten osaamme auttaa kun liität mukaan kuvan ongelmasta.